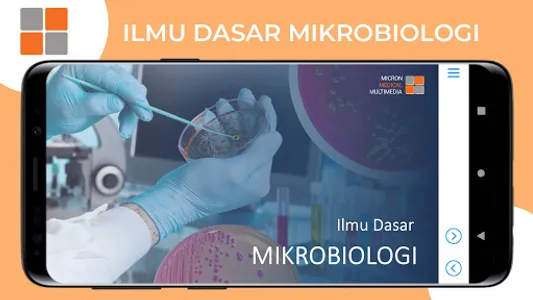
M3 Kesehatan: Ilmu Dasar Mikro screenshot 16

Before you download the application, please pay attention to the following points:
1. All M3 IDK applications in the Playstore can only be accessed by M3 IDK members.
2. For those who have not been registered as an M3 member and are interested in becoming a member, please contact the Administration at (021) 56967880 [there is a registration fee]
3. For those who are already members, please register in the application according to your member data, (registration requires an internet connection)
Basic Science of Microbiology Consists of 3 discussion topics including:
1. Introduction to Microbiology
2. Bacteria
3. Viruses
1. All M3 IDK applications in the Playstore can only be accessed by M3 IDK members.
2. For those who have not been registered as an M3 member and are interested in becoming a member, please contact the Administration at (021) 56967880 [there is a registration fee]
3. For those who are already members, please register in the application according to your member data, (registration requires an internet connection)
Basic Science of Microbiology Consists of 3 discussion topics including:
1. Introduction to Microbiology
2. Bacteria
3. Viruses
Show More